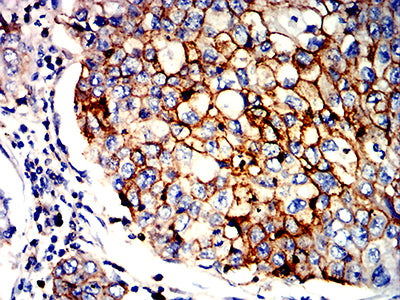

-
分类: 科研抗体货号: 32265别名:应用: IHC,IF,FCM反应种属: Human
-
分类: 科研抗体货号: 32288别名: AZ3B; C3AR; HNFAG09应用: FCM反应种属: Human
-
分类: 科研抗体货号: 32278别名: PM227; AHNAKRS应用: IF,FCM反应种属: Human
-
分类: 科研抗体货号: 32287别名: FDH; FTHFD; 10-fTHF; 10-FTHFDH应用: WB,IHC,FCM反应种属: Human, Rat
-
分类: 科研抗体货号: 32292别名: P35; UP3B; UPIIIB应用: FCM反应种属: Human
-
分类: 科研抗体货号: 32277别名: PM227; AHNAKRS应用: IHC,IF,FCM反应种属: Human
-
分类: 科研抗体货号: 32286别名: FDH; FTHFD; 10-fTHF; 10-FTHFDH应用: WB,IHC,FCM反应种属: Human, Mouse, Rat
-
分类: 科研抗体货号: 32291别名: hK2; hGK-1; KLK2A2应用: IHC,IF,FCM反应种属: Human
-
分类: 科研抗体货号: 32301别名: CSA; MOT; MOT2; SAAN; CRP40; EVPLS; GRP75; PBP74; GRP-75; HSPA9B; SIDBA4; MTHSP75; HEL-S-124m应用: WB,IHC,IF,FCM反应种属: Human, Mouse, Monkey, Rat
-
分类: 科研抗体货号: 32285别名:应用: IHC,IF,FCM反应种属: Human

鄂公网安备42018502007531号
鄂公网安备42018502007531号

